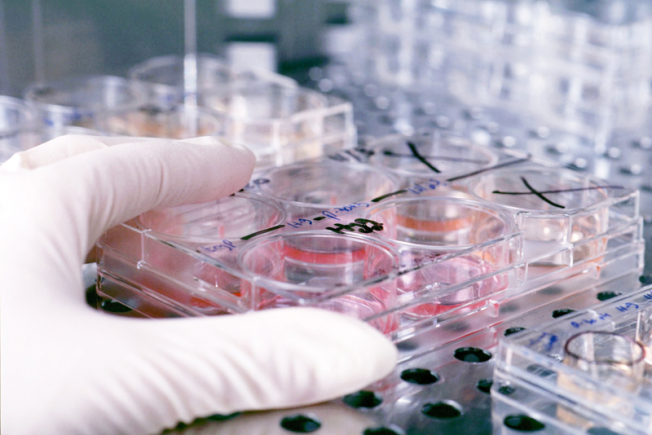

Human Tissue for Safety Pharmacology
At a glance
Contents
Overview
What is safety pharmacology?
It is a regulatory requirement that all drugs intended for human use go through safety pharmacology studies to determine the potential for adverse effect liabilities in major organ systems, including respiratory, cardiovascular and central nervous systems. This process currently relies on animal models, including mice, rats, dogs and non-human primates.
What is the NC3Rs’ role?
Together with the Medicines and Healthcare Products Regulatory Agency (MHRA) and 28 other organisations including pharmaceutical companies, contract research organisations and international regulators, the NC3Rs is working to increase the uptake of human tissue-based approaches to (1) replace the use of animals, and (2) provide more relevant and predictive tools to determine the safety of drugs entering clinical studies.
By supporting the development of technologies associated with human tissue use, and facilitating discussion and collaboration, the NC3Rs aims to strengthen the evidence base for human tissue use in safety assessment.
NC3Rs/SPS Regional Meeting: Barriers to the use of human tissue
In May 2017, the NC3Rs and Safety Pharmacology Society (SPS) organised an SPS regional meeting in collaboration with the University of Coventry. This one-day conference brought together scientists working with human tissue for safety assessment to discuss progress and remaining barriers to the implementation of human tissue models. The output has been published in the Journal of Pharmacological and Toxicological Methods.
Assessing the use of human tissue
In 2013 the NC3Rs and SPS assessed the use of human tissue through a survey of the international safety pharmacology community which highlighted that human tissue use for safety assessment is currently limited, but there is increasing interest in adopting this approach.
In 2017, the NC3Rs repeated the survey to assess progress and identify focuses for future work. 69 respondents provided information on human tissue approaches for safety assessment. 63% reported an increase in human tissue use since 2013, representing models from cardiovascular, hepatic, respiratory and gastrointestinal, nervous system and renal safety assessment.
Resource and case studies: Increasing human tissue use
We have a dedicated resource page: Increasing human tissue use which includes information on improving access to human tissue and navigating the regulatory and ethical framework.
It also features a collection of case studies commissioned to illustrate how human tissue is used in safety pharmacology, in order to provide examples of current practice and guide others using these techniques.
Regulator’s Q&A document: Human tissue use in regulatory applications
The NC3Rs has convened an international group of regulators to produce a consensus question and answer (Q&A) document about the use of human tissue for safety assessment, which demonstrates how researchers can use human tissue data to support regulatory applications. Participants were:
- UK Medicines and Healthcare Products Regulatory Agency
- Belgian Federal Agency for Medicines and Health Products
- German Federal Institute for Drugs and Medical DevicesFinnish Medicines Agency
Publications
- Holmes A, Bonner, F, Jones D (2015) Assessing drug safety in human tissues - what are the barriers? Nat Rev Drug Disc Vol. 14, pp585-587. DOI 10.1038/nrd4662.
- Jackson SJ, Prior H, Holmes A (2018) The Use of Human Tissue in Safety Assessment J Pharm Tox Meth Vol. 93, pp29-34. DOI 10.1016/j.vascn.2018.05.003.